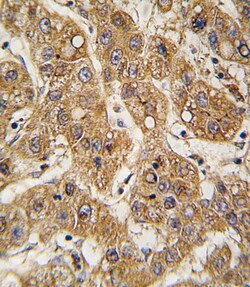

Promotional price valid on web orders only. Your contract pricing may differ. Interested in signing up for a dedicated account number?
Learn More
Learn More
Invitrogen™ APOE Polyclonal Antibody


Rabbit Polyclonal Antibody
Supplier: Invitrogen™ PA514539
Description
This antibody is predicted to react with non-human primate and rabbit based on sequence homology.
Apo E (Apolipoprotein E) plays an important role in the metabolism of lipids in the plasma, and is also is a constituent of various plasma lipoprotein-lipid particles. The protein is synthesized in liver, brain, spleen, and the kidney, and concentrations are high in interstitial fluids, where it plays a role in distributing cholesterol from cells where cholesterol is in excess to cells which require cholesterol. Apo E also plays an important role in the formation of very low density lipoprotein and chylomicrons. The Apo E gene is located on chromosome 19 at position 19q13. 2.
Specifications
| APOE | |
| Polyclonal | |
| Unconjugated | |
| APOE | |
| AD2; AI255918; APOE; apo-E; ApoE4; APOEA; Apolipoprotein; apolipoprotein E; apolipoprotein E3; apolipoprotein E4; Apoprotein; B2G1; BG; LDLCQ5; LPG; MGC1571 | |
| Rabbit | |
| Affinity chromatography, Antigen affinity chromatography, Protein A | |
| RUO | |
| 11816, 348 | |
| Store at 4°C short term. For long term storage, store at -20°C, avoiding freeze/thaw cycles. | |
| Liquid |
| Immunohistochemistry (Paraffin), Western Blot | |
| 0.5 mg/mL | |
| PBS with 0.09% sodium azide; pH 7.4 | |
| P02649, P08226 | |
| APOE | |
| KLH conjugated synthetic peptide between 263-292 amino acids from the C-terminal region of human APOE. | |
| 400 μL | |
| Primary | |
| Human, Mouse | |
| Antibody | |
| IgG |
Product Content Correction
Your input is important to us. Please complete this form to provide feedback related to the content on this product.
Product Title
Spot an opportunity for improvement?Share a Content Correction